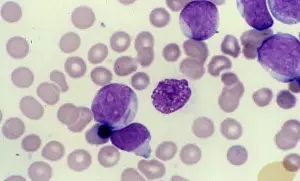
圖片

115年:(醫檢)血液(1)
某白血病病患的骨髓抹片如圖所示,經流式細胞儀分析,其blast之細胞表面標記的結果為CD33(+)、CD117(+) ,則此病人最有可能罹患下列何種疾病?
Aacute lymphoblastic leukemia (ALL)
Bchronic lymphocytic leukemia (CLL)
Cacute myeloid leukemia (AML)
Dchronic myeloid leukemia (CML)
詳細解析
本題觀念:
急性骨髓性白血病 (AML) 的診斷整合:形態學 (Morphology) 與 免疫表現型 (Immunophenotype)。 本題考查重點在於辨識骨髓抹片中的芽細胞 (Blasts) 特徵,並結合流式細胞儀 (Flow cytometry) 的 CD marker 結果來進行鑑別診斷。
影像分析:
-
低倍鏡視野 (圖一/左圖):
- 顯示骨髓呈現 極度高細胞性 (Hypercellularity)。
- 正常的脂肪空泡 (Fat spaces) 幾乎完全消失,被單調均一的細胞群 (Monotonous population) 取代,這是急性白血病的典型骨髓表現(Packed marrow)。
-
高倍鏡視野 (圖二/右圖):
- 視野中充滿了體積較大、核質比 (N/C ratio) 高的 芽細胞 (Blasts)。
- 細胞核特徵:核染色質呈現細緻、疏鬆的網狀結構 (Fine, lacy chromatin),且可見明顯的 核仁 (Nucleoli),這是細胞未成熟的特徵。
- 細胞質特徵:細胞質呈現嗜鹼性(藍色)。值得注意的是,在典型的 AML 考題影像中,若仔細觀察細胞質,有時可見細小的顆粒或紅色的針狀包涵體 —— 奧爾氏棒 (Auer rods)。雖然單憑圖片解析度未必能確認 Auer rod,但這些細胞的形態學特徵強烈提示為骨髓系來源的芽細胞 (Myeloblasts)。
選項分析:
-
(A) acute lymphoblastic leukemia (ALL):
- 錯誤。ALL 的芽細胞 (Lymphoblasts) 雖然形態上可能相似(高 N/C ratio),但其流式細胞儀標記應為 B-cell (CD19, CD10, CD22, TdT) 或 T-cell (CD3, CD7, CD5) 相關抗原。
- 題目中的 CD33(+) 和 CD117(+) 是骨髓系 (Myeloid) 的典型標記,且 CD117 在 ALL 中極少表現(除了少數 ETP-ALL,但那通常伴隨 T cell marker)。
-
(B) chronic lymphocytic leukemia (CLL):
- 錯誤。CLL 的特徵是 成熟 的小淋巴球 (Small mature lymphocytes) 增生,染色質會呈現緊密結塊狀 (Clumped chromatin),且常見破裂的 Smudge cells。
- 免疫標記應為 CD5(+), CD19(+), CD23(+)。題目中的 Blast 形態與未成熟標記與 CLL 完全不符。
-
(C) acute myeloid leukemia (AML):
- 正確。
- 免疫標記佐證:
- CD33:是泛骨髓系抗原 (Pan-myeloid marker),在絕大多數 AML 中表現。
- CD117 (c-kit):是幹細胞因子受體,表現於造血幹細胞及 骨髓芽細胞 (Myeloblasts)。CD117 對於區分 AML 與 ALL 非常有用,因為它在 AML 中具高敏感度與特異度,而在 ALL 中通常為陰性。
- 形態學佐證:影像顯示骨髓被芽細胞佔據,且標記證實其為骨髓來源,故診斷為 AML。
-
(D) chronic myeloid leukemia (CML):
- 錯誤。CML 的典型病程(慢性期)特徵是各階段成熟度的顆粒球(從 Blast 到 Segmented neutrophils)同時存在,且 Blast 比例通常 < 20%。
- 雖然 CML 進入 急性轉化期 (Blast crisis) 時可能出現類似 AML 的表現,但 CML 的診斷核心在於費城染色體 (Ph chromosome) 或 BCR-ABL 基因融合。在沒有提及慢性病史、脾腫大或 Ph 染色體的情況下,且面對一個以「芽細胞」為主的骨髓象,AML 是最直接且正確的診斷。
答案解析
本題病患骨髓抹片顯示大量芽細胞增生,流式細胞儀分析結果為 CD33(+) 與 CD117(+)。
- CD33 確認細胞屬於 骨髓系 (Myeloid lineage)。
- CD117 確認細胞具有 未成熟/幹細胞特性 (Immaturity)。
- 此組合 (Myeloid + Blast) 加上骨髓中大量芽細胞的形態,符合 Acute Myeloid Leukemia (AML) 的診斷標準。故正確答案為 (C)。
核心知識點
- AML 關鍵免疫標記 (Immunophenotype):
- 陽性:MPO (最特異), CD13, CD33, CD117 (c-kit), CD34, HLA-DR。
- 陰性:CD3 (T-cell), CD19 (B-cell)。
- AML 形態學特徵:
- Myeloblasts 大小不一,核染色質細緻,可見核仁。
- Auer rods (奧爾氏棒):若在細胞質中發現此紅色針狀構造,為 AML 的 病理性特徵 (Pathognomonic),可直接確診為 AML (或高階 MDS)。
- 鑑別診斷速記:
- CD117(+) / CD33(+) AML
- TdT(+) / CD10(+) / CD19(+) B-ALL
- TdT(+) / CD3(+) / CD7(+) T-ALL
參考資料
- Flow Cytometry in the Diagnosis of Leukemias. NCBI. Link (CD33, CD117 expression in AML)
- Diagnostic value of CD117 in differential diagnosis of acute leukemias. PubMed. (CD117 specificity for AML vs ALL)
- Auer rods - American Society of Hematology Image Bank.